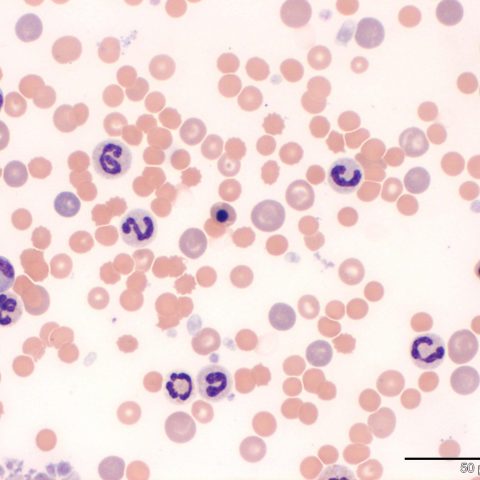

Haematology & Coagulation
Haematology
There is true science behind producing the numerical data and at Cytopath Limited we are fully cognisant with instrument limitations and the interferences that can be introduced as a result of pathological states. Additionally, our pathologists perform all the blood smear examinations and this fact stands us apart from our competitors. Our pathologists are not sited at remote computer terminals but remain hands-on at Cytopath and this is why we are confident that our haematology results are accurate, their interpretation is reliable, and we can give you that bit extra which often makes the difference. We offer full blood counts, smear examinations, reticulocyte counts, manual platelet counts and other complementary diagnostic modalities including Coombs tests, urinalyses and coagulation testing.
Coagulation
We currently offer prothrombin time (PT) and activated partial thromboplastin time (aPTT) to aid the investigation of bleeding disorders.